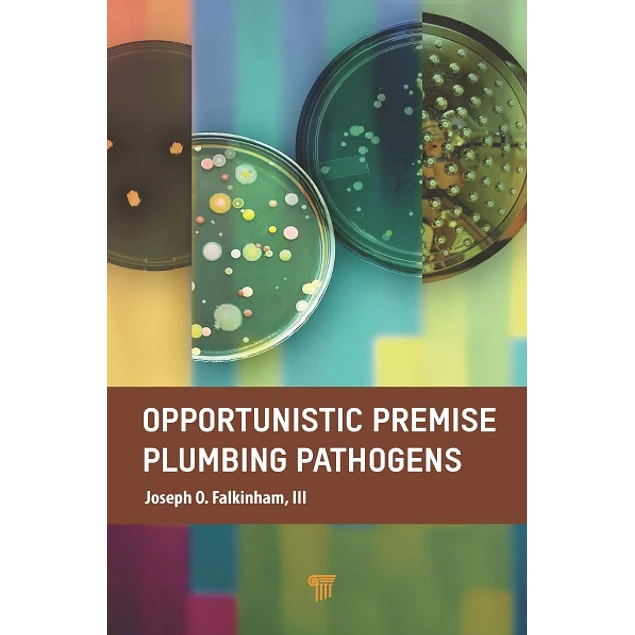

Description
Legionella pneumophila, Pseudomonas aeruginosa, and Mycobacterium avium are water-borne opportunistic premise plumbing pathogens (OPPPs) that cause human disease of great economic cost. The incidence and prevalence of OPPP-disease caused by these three exemplary OPPPs is increasing at alarming rates.
As the first book-length review of OPPPs, this book describes the shared characteristics of the emerging group of water-borne pathogens that are normal inhabitants of drinking water systems and premise plumbing. It discusses the selective conditions of drinking water distribution systems and premise plumbing that have led to the emergence of OPPPs. The text also reviews the results of the studies that describe microbial adaptations leading to survival, persistence, and growth in drinking water distribution systems and premise plumbing.

Reviews
There are no reviews yet.